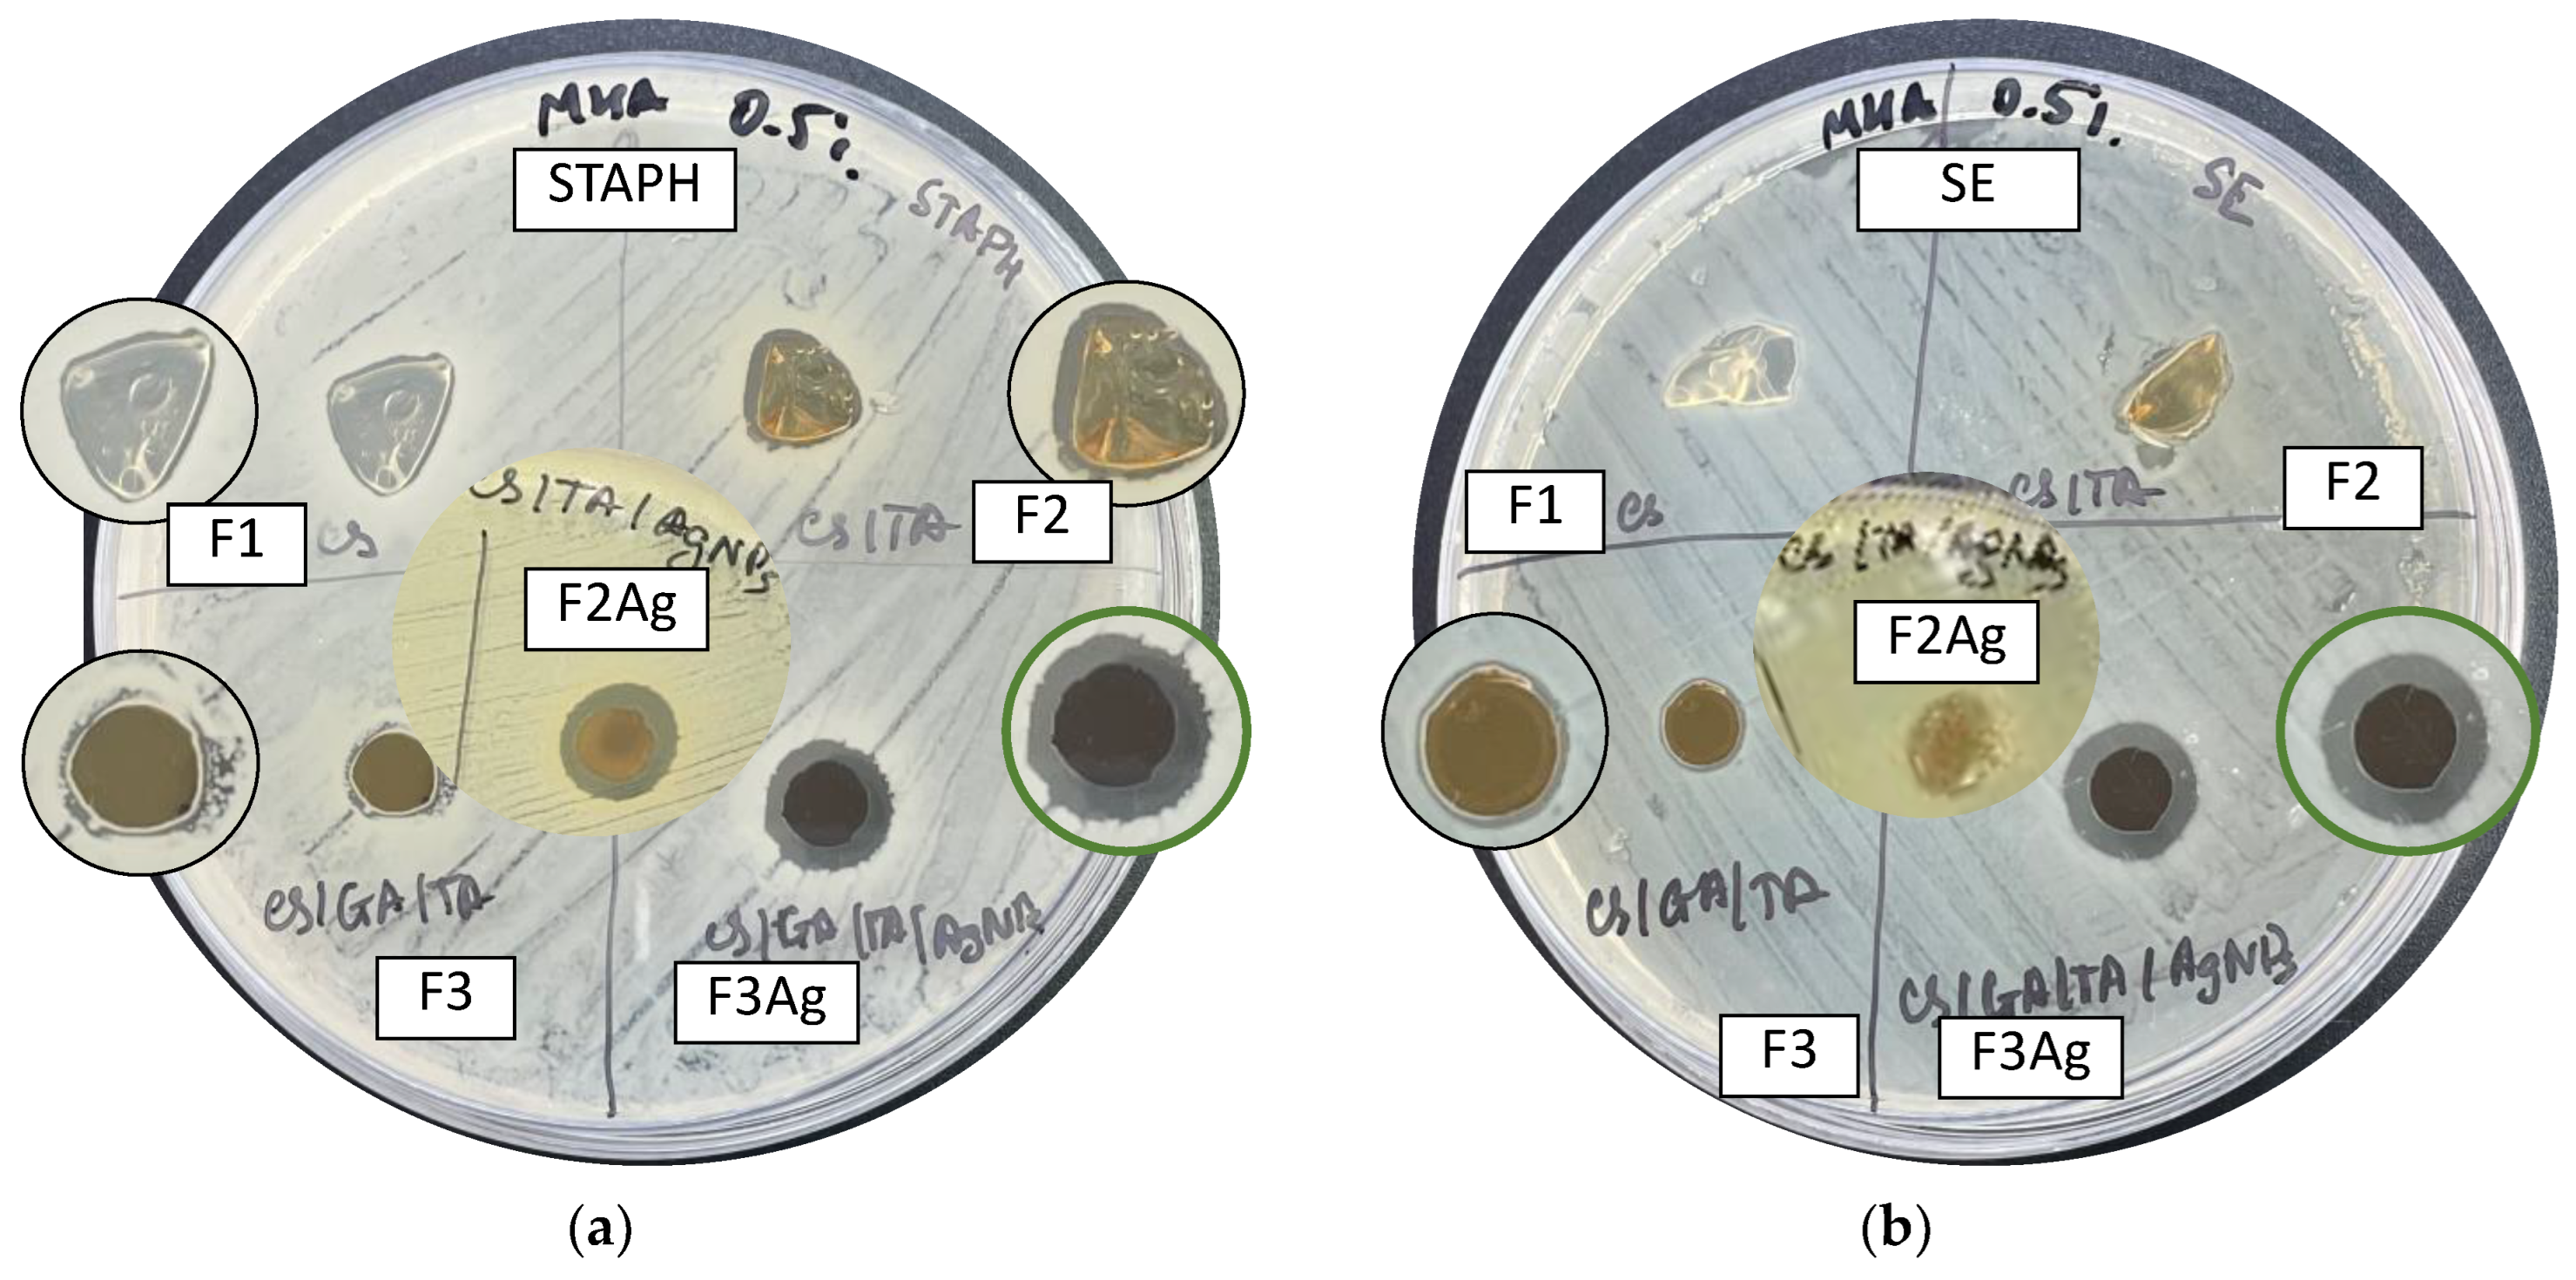

Self-Standing Bioinspired Polymer Films Doped with Ultrafine Silver Nanoparticles as Innovative Antimicrobial Material
Abstract
1. Introduction
2. Results and Discussion
2.1. Preparation of Hybrid Films
2.2. Microscopic Characterization of Thin Films
2.2.1. Optical Microscopy and Visual Appearance
2.2.2. Morphological Study: Scanning Electron Microscopy (SEM)
2.3. Water Uptake Measurements of Reinforced Polymer Films
2.4. Thermal Stability of Thin Films: Thermogravimetric Analysis (TGA)
2.5. Spectroscopic Characterization of the Films
2.5.1. Fourier Transform Infrared (FTIR) Spectroscopy
2.5.2. Surface Analysis by X-ray Photoelectron Spectroscopy (XPS)
2.6. Antimicrobial Tests
2.6.1. Optimization of Test Conditions
2.6.2. Disk Diffusion Method to Test Developed Films against Foodborne Pathogens
3. Materials and Methods
3.1. Materials and Preparation of Hybrid Films
3.2. Morphology and Particle Distribution
3.3. Water Uptake Measurements
3.4. Thermogravimetric Analysis
3.5. Fourier Transform Infrared Spectroscopy
3.6. X-ray Photoelectron Spectroscopy
3.7. Antimicrobial Activity
4. Conclusions
Supplementary Materials
Author Contributions
Funding
Institutional Review Board Statement
Informed Consent Statement
Data Availability Statement
Acknowledgments
Conflicts of Interest
References
- Murray, C.J.; Ikuta, K.S.; Sharara, F.; Swetschinski, L.; Aguilar, G.R.; Gray, A.; Han, C.; Bisignano, C.; Rao, P.; Wool, E.; et al. Global Burden of Bacterial Antimicrobial Resistance in 2019: A Systematic Analysis. Lancet 2022, 399, 629–655. [Google Scholar] [CrossRef] [PubMed]
- Aslam, B.; Wang, W.; Arshad, M.I.; Khurshid, M.; Muzammil, S.; Rasool, M.H.; Nisar, M.A.; Alvi, R.F.; Aslam, M.A.; Qamar, M.U.; et al. Antibiotic Resistance: A Rundown of a Global Crisis. Infect. Drug Resist. 2018, 11, 1645–1658. [Google Scholar] [CrossRef] [PubMed]
- Kumar, M.; Sarma, D.K.; Shubham, S.; Kumawat, M.; Verma, V.; Nina, P.B.; JP, D.; Kumar, S.; Singh, B.; Tiwari, R.R. Futuristic Non-Antibiotic Therapies to Combat Antibiotic Resistance: A Review. Front. Microbiol. 2021, 12, 609459. [Google Scholar] [CrossRef] [PubMed]
- Rao, H.; Choo, S.; Rajeswari Mahalingam, S.R.; Adisuri, D.S.; Madhavan, P.; Md. Akim, A.; Chong, P.P. Approaches for Mitigating Microbial Biofilm-Related Drug Resistance: A Focus on Micro- and Nanotechnologies. Molecules 2021, 26, 1870. [Google Scholar] [CrossRef] [PubMed]
- Moo, C.-L.; Yang, S.-K.; Yusoff, K.; Ajat, M.; Thomas, W.; Abushelaibi, A.; Lim, S.-H.-E.; Lai, K.-S. Mechanisms of Antimicrobial Resistance (AMR) and Alternative Approaches to Overcome AMR. Curr. Drug Discov. Technol. 2020, 17, 430–447. [Google Scholar] [CrossRef]
- Nile, S.H.; Baskar, V.; Selvaraj, D.; Nile, A.; Xiao, J.; Kai, G. Nanotechnologies in Food Science: Applications, Recent Trends, and Future Perspectives. Nano-Micro Lett. 2020, 12, 45. [Google Scholar] [CrossRef]
- Kukushkina, E.A.; Hossain, S.I.; Sportelli, M.C.; Ditaranto, N.; Picca, R.A.; Cioffi, N. Ag-Based Synergistic Antimicrobial Composites. A Critical Review. Nanomaterials 2021, 11, 1687. [Google Scholar] [CrossRef]
- Ribeiro, A.I.; Dias, A.M.; Zille, A. Synergistic Effects Between Metal Nanoparticles and Commercial Antimicrobial Agents: A Review. ACS Appl. Nano Mater. 2022, 5, 3030–3064. [Google Scholar] [CrossRef]
- Anees Ahmad, S.; Sachi Das, S.; Khatoon, A.; Tahir Ansari, M.; Afzal, M.; Saquib Hasnain, M.; Kumar Nayak, A. Bactericidal Activity of Silver Nanoparticles: A Mechanistic Review. Mater. Sci. Energy Technol. 2020, 3, 756–769. [Google Scholar] [CrossRef]
- Kędziora, A.; Wieczorek, R.; Speruda, M.; Matolínová, I.; Goszczyński, T.M.; Litwin, I.; Matolín, V.; Bugla-Płoskońska, G. Comparison of Antibacterial Mode of Action of Silver Ions and Silver Nanoformulations With Different Physico-Chemical Properties: Experimental and Computational Studies. Front. Microbiol. 2021, 12, 1707. [Google Scholar] [CrossRef]
- Yin, I.X.; Zhang, J.; Zhao, I.S.; Mei, M.L.; Li, Q.; Chu, C.H. The Antibacterial Mechanism of Silver Nanoparticles and Its Application in Dentistry. Int. J. Nanomed. 2020, 15, 2555–2562. [Google Scholar] [CrossRef]
- Kukushkina, E.A.; Mateos, H.; Altun, N.; Sportelli, M.C.; Gonzalez, P.; Picca, R.A.; Cioffi, N. Highly Stable Core-Shell Nanocolloids: Synergy between Nano-Silver and Natural Polymers to Prevent Biofilm Formation. Antibiotics 2022, 11, 1396. [Google Scholar] [CrossRef]
- Yuan, Y.; Ding, L.; Chen, Y.; Chen, G.; Zhao, T.; Yu, Y. Nano-Silver Functionalized Polysaccharides as a Platform for Wound Dressings: A Review. Int. J. Biol. Macromol. 2022, 194, 644–653. [Google Scholar] [CrossRef]
- Kaczmarek, B. Tannic Acid with Antiviral and Antibacterial Activity as A Promising Component of Biomaterials—A Minireview. Materials 2020, 13, 3224. [Google Scholar] [CrossRef]
- An, J.; Luo, Q.; Yuan, X.; Wang, D.; Li, X. Preparation and Characterization of Silver-Chitosan Nanocomposite Particles with Antimicrobial Activity. J. Appl. Polym. Sci. 2011, 120, 3180–3189. [Google Scholar] [CrossRef]
- Thanh, N.T.K.; Maclean, N.; Mahiddine, S. Mechanisms of Nucleation and Growth of Nanoparticles in Solution. Chem. Rev. 2014, 114, 7610–7630. [Google Scholar] [CrossRef]
- Szymańska, E.; Winnicka, K. Stability of Chitosan—A Challenge for Pharmaceutical and Biomedical Applications. Mar. Drugs 2015, 13, 1819–1846. [Google Scholar] [CrossRef]
- Roy, S.; Zhai, L.; Kim, H.C.; Pham, D.H.; Alrobei, H.; Kim, J. Tannic-Acid-Cross-Linked and TiO2-Nanoparticle-Reinforced Chitosan-Based Nanocomposite Film. Polymers 2021, 13, 228. [Google Scholar] [CrossRef]
- Eulalio, H.Y.C.; Rodrigues, J.F.B.; Santos, K.O.; Peniche, C.; LiaFook, M.V. Characterization and Thermal Properties of Chitosan Films Prepared with Different Acid Solvents. Rev. Cuba. Quím. 2019, 31, 309–323. [Google Scholar]
- Shah, R.; Stodulka, P.; Skopalova, K.; Saha, P. Dual Crosslinked Collagen/Chitosan Film for Potential Biomedical Applications. Polymers 2019, 11, 2094. [Google Scholar] [CrossRef]
- Rubentheren, V.; Ward, T.A.; Chee, C.Y.; Nair, P. Physical and Chemical Reinforcement of Chitosan Film Using Nanocrystalline Cellulose and Tannic Acid. Cellulose 2015, 22, 2529–2541. [Google Scholar] [CrossRef]
- Dara, P.K.; Mahadevan, R.; Digita, P.A.; Visnuvinayagam, S.; Kumar, L.R.G.; Mathew, S.; Ravishankar, C.N.; Anandan, R. Synthesis and Biochemical Characterization of Silver Nanoparticles Grafted Chitosan (Chi-Ag-NPs): In Vitro Studies on Antioxidant and Antibacterial Applications. SN Appl. Sci. 2020, 2, 665. [Google Scholar] [CrossRef]
- Arif, D.; Niazi, M.B.K.; Ul-Haq, N.; Anwar, M.N.; Hashmi, E. Preparation of Antibacterial Cotton Fabric Using Chitosan-Silver Nanoparticles. Fibers Polym. 2015, 16, 1519–1526. [Google Scholar] [CrossRef]
- Vieira, R.S.; Oliveira, M.L.M.; Guibal, E.; Rodríguez-Castellón, E.; Beppu, M.M. Copper, Mercury and Chromium Adsorption on Natural and Crosslinked Chitosan Films: An XPS Investigation of Mechanism. Colloids Surf. Physicochem. Eng. Asp. 2011, 374, 108–114. [Google Scholar] [CrossRef]
- Sportelli, M.C.; Volpe, A.; Picca, R.A.; Trapani, A.; Palazzo, C.; Ancona, A.; Lugarà, P.M.; Trapani, G.; Cioffi, N. Spectroscopic Characterization of Copper-Chitosan Nanoantimicrobials Prepared by Laser Ablation Synthesis in Aqueous Solutions. Nanomaterials 2017, 7, 6. [Google Scholar] [CrossRef] [PubMed]
- Cioffi, N.; Colaianni, L.; Pilolli, R.; Calvano, C.D.; Palmisano, F.; Zambonin, P.G. Silver Nanofractals: Electrochemical Synthesis, XPS Characterization and Application in LDI-MS. Anal. Bioanal. Chem. 2009, 394, 1375–1383. [Google Scholar] [CrossRef]
- Picca, R.A.; Calvano, C.D.; Lo Faro, M.J.; Fazio, B.; Trusso, S.; Ossi, P.M.; Neri, F.; D’Andrea, C.; Irrera, A.; Cioffi, N. Functionalization of Silicon Nanowire Arrays by Silver Nanoparticles for the Laser Desorption Ionization Mass Spectrometry Analysis of Vegetable Oils. J. Mass Spectrom. 2016, 51, 849–856. [Google Scholar] [CrossRef]
- X-ray Photoelectron Spectroscopy Database XPS, Version 4.1, NIST Standard Reference Database. Available online: https://www.nist.gov/srd/surface-data (accessed on 31 October 2022).
- Lin, C.; Hsu, F.-Y.; Lin, W.-T.; Cha, C.-Y.; Ho, Y.-C.; Mi, F.-L. Biodegradable Nanoparticles Prepared from Chitosan and Casein for Delivery of Bioactive Polysaccharides. Polymers 2022, 14, 2966. [Google Scholar] [CrossRef]
- Ding, L.; Huang, Y.; Cai, X.; Wang, S. Impact of PH, Ionic Strength and Chitosan Charge Density on Chitosan/Casein Complexation and Phase Behavior. Carbohydr. Polym. 2019, 208, 133–141. [Google Scholar] [CrossRef]
- Koopmann, A.-K.; Schuster, C.; Torres-Rodríguez, J.; Kain, S.; Pertl-Obermeyer, H.; Petutschnigg, A.; Hüsing, N. Tannin-Based Hybrid Materials and Their Applications: A Review. Molecules 2020, 25, 4910. [Google Scholar] [CrossRef]
- Ke, C.-L.; Deng, F.-S.; Chuang, C.-Y.; Lin, C.-H. Antimicrobial Actions and Applications of Chitosan. Polymers 2021, 13, 904. [Google Scholar] [CrossRef]
- Girard, J.; Brunetto, P.S.; Braissant, O.; Rajacic, Z.; Khanna, N.; Landmann, R.; Daniels, A.U.; Fromm, K.M. Development of a Polystyrene Sulfonate/Silver Nanocomposite with Self-Healing Properties for Biomaterial Applications. Comptes Rendus Chim. 2013, 16, 550–556. [Google Scholar] [CrossRef]

| Composition of Thin Films | Sample Label |
|---|---|
| CS | F1 |
| CS/TA | F2 |
| CS/AgNPs | F1Ag |
| CS/TA/AgNPs | F2Ag |
| CS/GA/TA | F3 |
| CS/GA/TA/AgNPs | F3Ag |
| Functional Group | Wavenumber (cm −1) | Description |
|---|---|---|
| C=O | 1632 | Interactions of the amide group I (CONH2) with the functional groups of TA upon crosslinking cause pronounced C=O stretching |
| NH3+ symmetrical deformation | ~1540 | Interactions of CS with TA in acidic conditions cause ionization of the primary amino group II in the presence of carboxylic group |
| CH3 symmetrical deformation mode | 1405 | Changes of the relative peak intensities due to the interaction with TA |
| 1380 | ||
| C-N stretching | 1326 | Strong signal from TA, blue shift and decrease in the intensity due to the interaction with CS |
| C-O vibration | 1200 | Disappearance of the band upon addition of AgNPs |
| OH bending vibration | ~1145 | Due to the structure of the saccharide |
| C-O-C bonding vibrations | 1100–1000 | Peak separation changes due to the crosslinking and functional groups interaction |
| AgNPs | 826 | Interaction of AgNPs with O- and N-rich functional groups |
| Sample Composition | F3 (CS/GA/TA) | F2Ag (CS/TA/AgNPs) | F3Ag (CS/GA/TA/AgNPs) |
|---|---|---|---|
| Element | Atomic % | ||
| C | 74 ± 3 | 65.2 ± 0.5 | 69 ± 2 |
| O | 22 ± 2 | 25.6 ± 0.5 | 26.3 ± 1.5 |
| N | 3.6 ± 0.5 | 4.6 ± 0.5 | 4.5 ± 0.6 |
| Ag | / | 2.9 ± 0.2 | 0.2 ± 0.2 |
| Si | 0.4 ± 0.5 | 1.1 ± 0.5 | <0.5 |
| Ca | <0.5 | 0.6 ± 0.5 | <0.5 |
| I | <0.2 | <0.2 | <0.2 |
| Sample | Component | Assignment | Relative Abundance% |
|---|---|---|---|
| F3 | 284.8 | C-C, C-H | 50 ± 3 |
| 286.3 | C-O, C-N | 39 ± 4 | |
| 287.7 | O-C-O, C=O | 6.2 ± 0.9 | |
| 288.3 | COOH, N-C=O | 4.8 ± 0.7 | |
| F2Ag | 284.8 | C-C, C-H | 52 ± 5 |
| 286.4 | C-O, C-N | 36 ± 4 | |
| 287.9 | O-C-O, C=O | 10 ± 2 | |
| 288.9 | COOH, N-C=O | 2 ± 1 | |
| F3Ag | 284.8 | C-C, C-H | 47 ± 5 |
| 286.4 | C-O, C-N | 42 ± 4 | |
| 287.8 | O-C-O, C=O | 9 ± 2 | |
| 288.9 | COOH, N-C=O | 2 ± 1 |
| Sample | Composition | Zone of Inhibition of Fresh Sample, cm | Zone of Inhibition of Aged Sample, cm | ||
|---|---|---|---|---|---|
| S. aureus | S. enterica | S. aureus | S. enterica | ||
| F1 | CS | 0.7 ± 0.1 | 0.6 ± 0.1 | 0.6 ± 0.1 | 0.6 ± 0.1 |
| F2 | CS/TA | 0.7 ± 0.1 | 0.6 ± 0.1 | 0.6 ± 0.1 | 0.6 ± 0.1 |
| F3 | CS/GA/TA | 0.7 ± 0.1 | 0.7 ± 0.1 | 0.6 ± 0.1 | 0.6 ± 0.1 |
| F2Ag | CS/TA/AgNPs | 1.2 ± 0.1 | 1.1 ± 0.1 | 1.0 ± 0.1 | 1.1 ± 0.1 |
| F3Ag | CS/GA/TA/AgNPs | 1.2 ± 0.1 | 1.2 ± 0.1 | 1.2 ± 0.1 | 1.1 ± 0.1 |
Publisher’s Note: MDPI stays neutral with regard to jurisdictional claims in published maps and institutional affiliations. |
© 2022 by the authors. Licensee MDPI, Basel, Switzerland. This article is an open access article distributed under the terms and conditions of the Creative Commons Attribution (CC BY) license (https://creativecommons.org/licenses/by/4.0/).
Share and Cite
Kukushkina, E.A.; Duarte, A.C.; Tartaro, G.; Sportelli, M.C.; Di Franco, C.; Fernández, L.; García, P.; Picca, R.A.; Cioffi, N. Self-Standing Bioinspired Polymer Films Doped with Ultrafine Silver Nanoparticles as Innovative Antimicrobial Material. Int. J. Mol. Sci. 2022, 23, 15818. https://doi.org/10.3390/ijms232415818
Kukushkina EA, Duarte AC, Tartaro G, Sportelli MC, Di Franco C, Fernández L, García P, Picca RA, Cioffi N. Self-Standing Bioinspired Polymer Films Doped with Ultrafine Silver Nanoparticles as Innovative Antimicrobial Material. International Journal of Molecular Sciences. 2022; 23(24):15818. https://doi.org/10.3390/ijms232415818
Chicago/Turabian StyleKukushkina, Ekaterina A., Ana Catarina Duarte, Giuseppe Tartaro, Maria Chiara Sportelli, Cinzia Di Franco, Lucía Fernández, Pilar García, Rosaria Anna Picca, and Nicola Cioffi. 2022. "Self-Standing Bioinspired Polymer Films Doped with Ultrafine Silver Nanoparticles as Innovative Antimicrobial Material" International Journal of Molecular Sciences 23, no. 24: 15818. https://doi.org/10.3390/ijms232415818
APA StyleKukushkina, E. A., Duarte, A. C., Tartaro, G., Sportelli, M. C., Di Franco, C., Fernández, L., García, P., Picca, R. A., & Cioffi, N. (2022). Self-Standing Bioinspired Polymer Films Doped with Ultrafine Silver Nanoparticles as Innovative Antimicrobial Material. International Journal of Molecular Sciences, 23(24), 15818. https://doi.org/10.3390/ijms232415818

